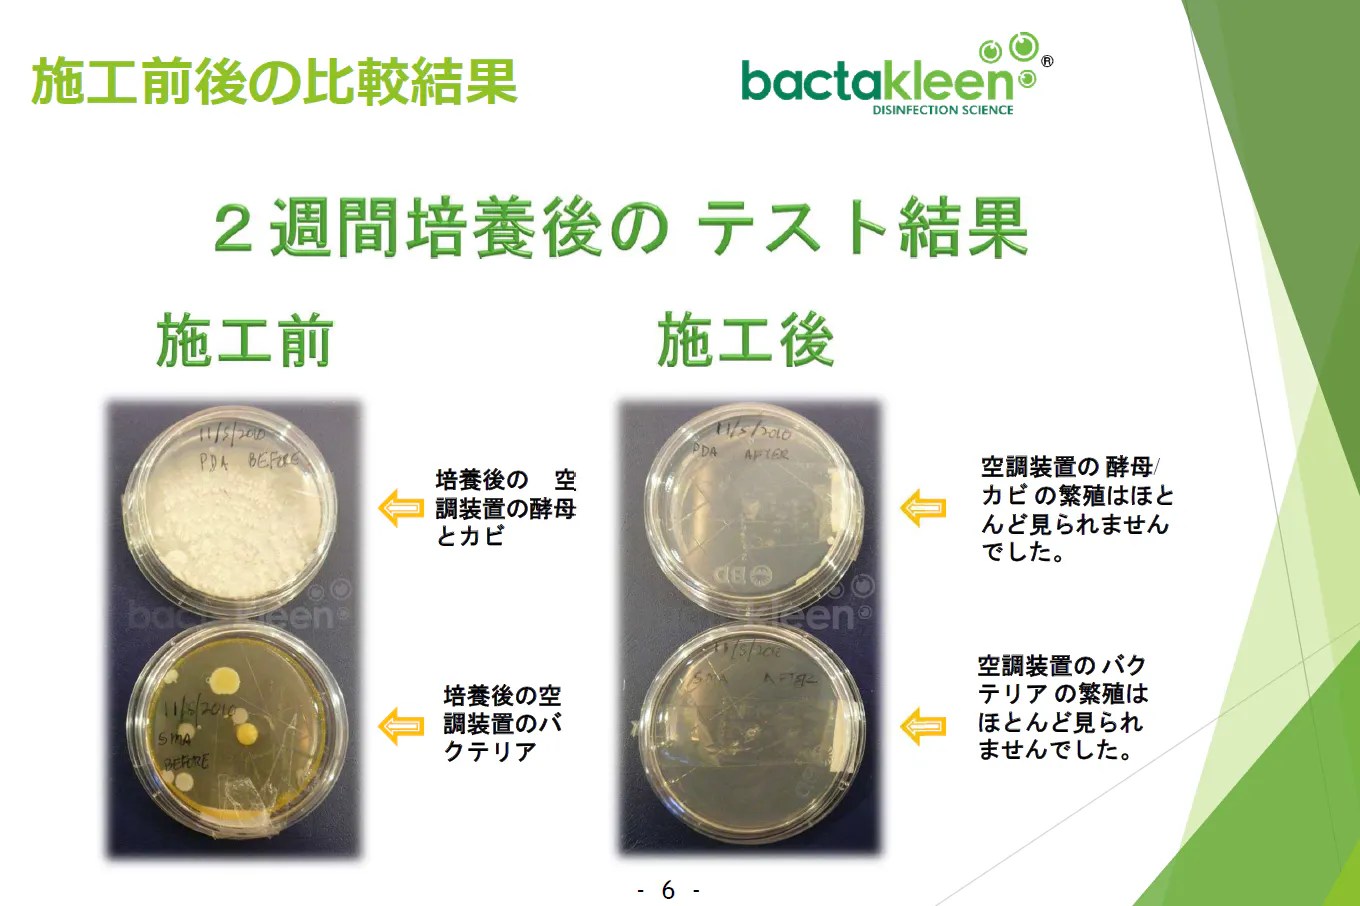

新型コロナが日本で爆発的に広まってから、3年目に突入しました。
当初はコロナ禍が終わり、元の生活に戻ることをイメージしていたわたしたちですが、この2年でコロナと共存していく方向に緩やかに変化しつつあります。いわゆるwithコロナ時代、通常の除菌は当たり前の事になりました。

お客様やスタッフ、家族や大切な人、愛するペットに更に安心して過ごしていただくために行っている、店舗やオフィス・自動車・バス・住宅などへの除菌も、コロナと共存することを考えると、継続して行わなければなりません。しかし、一般的な除菌システムでは、
✅継続して実施するには高すぎる!
✅施工準備や終わった後の原状復帰が大変!
✅施工そのものの時間が長い!
✅薬剤が人体に影響を及ぼす可能性があり!
✅第三者機関で効果が認証されているのかが不明
といった難点があり、継続するのは難しい…。
そこでご紹介したいのが、わたしたちK-PartnerLLCが扱っている【バクタクリーン】です!

【バクタクリーン】は、これらの問題すべてを解決できる、画期的な除菌システムです。 まだまだ知られていないこの製品を知っていただき、withコロナ時代のスタンダードとして様々なシーンで活用してほしい!と思い、このプロジェクトを立ち上げました。

K-PartnerLLCは、河村と石崎によるバクタクリーンを取り扱う合同会社です。
河村が広島、石崎が東京でそれぞれに除菌の事業を行っており、アルコール消毒から光触媒から次亜塩素酸・オゾン・紫外線まで、様々な除菌方法を取り入れてきました。
そんなところに突如起きたのが、コロナ禍でした。
新型コロナが広まらないよう、感染しないよう、ウイルス除去および抗ウイルス対策が日常となる、今まででは考えられない事態になったのです。人が集まる場所における除菌・抗菌・ウイルス除去・抗ウイルス対策は必須の対策となりました。

感染予防のための定期的な消毒に加え、感染者が出た場合は、施設内の共有部分や手が触れる可能性がある場所をすべて消毒しなければなりません。
しかし、これまでの対策だと、消毒した箇所が水分でびちゃびちゃになってしまうため、パソコンやその他の電化製品、そして本や書類など、濡れたら困るものはすべて撤去しなければなりません。消毒薬成分は人体に影響のあるものも多く、ふき取りをする必要があります。
また、除菌費用も高額なため、店舗や施設にとって大きな負担になっていました。

そんなとき、河村が偶然出会ったのがこの【バクタクリーン】でした。
除菌の仕方が何より革新的!最終形と言っても過言ではないものだったのです。
「この除菌・抗菌・ウイルス除去・抗ウイルス対策こそ、今必要とされているものだ!」
そう確信したわたしたちは意気投合して事業を起こし、昨年11月、K-PartnerLLC として法人化するに至りました。そして、この【バクタクリーン】をもっとたくさんの人に知ってもらい、活用してもらいたい!そういう思いから、このプロジェクトを立ち上げることにしたのです。
【バクタクリーン】は、なにより素晴らしい除菌システムだと、わたしたちは確信しています。
従来の除菌システムでも除菌は可能です。しかし、細かいところは難しかったり、ふき取りが必要だったり、事前準備が大変だったり価格が高かったりと、満点をつけられる方法はありませんでした。
この【バクタクリーン】は、それら欠点を軒並み解決して総合点で他を大きく上回る、画期的なシステムです!是非その特徴をご確認ください。

一番の大きな違いは、その除菌方法。お風呂の燻煙剤などと同じように煙(ナノ単位のミスト)を使うことで、細かい部分の除菌抗菌が可能です。これまでの方法では行き届かなかったエアコンの内部をはじめ、手の届かない奥の奥まで届きます。
バクタクリーンの煙(ナノ単位のミスト) はカビ抑制や臭いを抑える効果もあり、一石二鳥です!

※全ての菌を殺菌・除菌するわけではありません。

ボタニカル(植物由来)の100%天然成分からなるバクタクリーンウルトラミストは人に優しく、あらゆる表面の場所に使えて、ふき取りなどをする必要がありません。煙(ナノ単位のミスト)が広がり表面にコーティングされ、その効果が約3か月間持続します。
香りも天然成分そのままの、アロマのような優しい香り。天然成分しか使っていないので、学校・保育園・幼稚園の校舎や送迎バスの除菌にもおすすめです。


煙(ナノ単位のミスト)なので、水分に弱い電化製品や書類などを一切動かす必要がありません。設備や備品・パソコンなど、現状のまま施工が可能です。電化製品や革製品など水を使えないモノだらけの自動車への施工もOK!噴霧して締め切っておくだけの簡単施工です。


施工した時だけでなく、効果が持続している間は菌やウイルスを不活性化することが、世界的な様々な第三者検査機関で認証されています。

※全ての菌を殺菌・除菌するわけではありません。

【バクタクリーン】は、従来の除菌方法に比べて低コストで簡単にあらゆる場所に施工出来ます。
現在、東京都で10~15坪ほどの店舗の消毒を行う場合、光触媒なら15万円ほどかかるところ、【バクタクリーン】ならなんと4.5万円で対応可能です。地方の場合は経費が下がるため、もっとお安く対応しています。
感染症が発症した際の「事後除菌」だけでなく、感染予防対策として事前の「予防除菌」として継続的な消毒を行うことで、お客様に安心してご利用いただくことができます。もちろん、施工証明書込みで対応いたします。
更に、消毒対象設備が東京都にある法人様であれば、東京都の助成金を使って【バクタクリーン】での除菌が可能です。会社が東京都でなくても店舗や事務所が東京都にある場合、適用対象となります。この助成金について詳しくは、K-PertnerLLCお問い合わせフォームよりお問い合わせください。
バクタクリーン除菌システムの使用例、ぜひ動画でご覧くださいませ。

ぜひ、画期的除菌システム【バクタクリーン】をお試しください!
一番簡単にお試しいただけるのは、建物もしくはバスに対する施工です。広島市内、もしくは東京駅から100km圏内の建物、もしくはバスにバクタクリーンを施工いたします(交通費別途)。施工証明書付きですので、安心です。

または、バクタクリーンを5ヶ月間継続してお試しできるリターンはいかがでしょうか。噴霧器1台レンタルと、ウルトラミストを5本お届けします。様々なものを消毒して、その効果を実感してください。
バクタクリーン噴霧器とウルトラミスト1本のセットをご購入いただけるリターンもございます。必要な時にウルトラミストを追加購入していただければ、効率よく除菌が可能です。
その他のリターン、およびリターン詳細についてはリターン一覧をご覧ください。

皆様からご支援いただいた資金は全額、大切に使わせていただきます。
まずは最初のゴールとして、除菌で困っている施設にバクタクリーンを広めるための
・バクタクリーン仕入れ販売費用(約50万円)
を設定いたします。
多数のご支援をいただき、支援金がそれ以上に集まった際には、除菌で困っている施設にバクタクリーンを広めるための
・バクタクリーン広告宣伝費用(約50万円)
をネクストゴールに設定したいと思います。
万が一、その金額も上回ってご支援いただいた際には、さらに全国の皆様に知っていただくための活動資金として活用させていただきます。
※ご支援いただいた資金のうち、17%はCAMPFIRE手数料として納入いたします。
《スケジュール》
4月下旬 クラウドファンディング開始
5月30日 クラウドファンディング終了
6月~ リターンの日程調整開始
7月~ 準備でき次第、順次リターン発送

新型コロナウイルスが日本に上陸し、最初の緊急事態宣言が出たのは2020年4月7日でした。
あれから2年が経ちましたが、新型コロナが収まる気配はありません。
職場でクラスターが発生したら、お店のお客様が、スタッフが新型コロナに感染したら、家族が新型コロナにかかったら…。除菌が必要になったとき、なにをどう選べばいいかわからない方、たくさんいらっしゃるのではないでしょうか。
除菌残りがなく、ボタニカル(植物由来)だから安心で安全で、すぐ施工できて低価格、という、いいことづくめの【バクタクリーン】。飲食店のような食器や調理器具がある場所、塾や学校など紙類がたくさんある場所、病院や美容院、ライブハウスなど電化製品がたくさんある場所など、様々な除菌しづらい場所に、バクタクリーンの煙(ナノ単位のミスト)は効果を発揮します。
施工例:ライブハウスその1
施工例:ライブハウスその2
施工例:空手道場
感染予防対策として事前の「予防除菌」に、感染症が発症したお家や職場等には感染拡大を防ぐための「事後除菌」に最適です。ぜひあなたの職場で、店舗で、車でご自宅で、【バクタクリーン】の良さを体験してみてください。
ボタニカル(植物由来)で人にも時間にもお財布にも優しい【バクタクリーン】をどんどん使っていただき、withコロナ時代の備えとしてほしい、と心の底から思っております。わたしたちK-PartnerLLCの思いにご賛同いただき、暖かい応援をいただけれれば感無量です。皆様、どうぞよろしくお願いします。
K-PartnerLLC 河村・石崎
<バクタクリーン代理店になりませんか>
バクタクリーンを導入したいとお考えの方、バクタクリーン施工を事業としてお考えの方はいらっしゃいませんか?バクタクリーン代理店になることで、導入の際の負担が軽減され、営利目的での利用が可能となります。
条件その他、ご興味をお持ちの方はぜひ、当社までお気軽にご連絡くださいませ。
※掲載写真は、フリー素材もしくは許可をいただいたものを使用しています。
※本プロジェクトはAll-in方式で実施します。目標金額に満たない場合も、計画を実行し、リターンをお届けします。






コメント
もっと見る